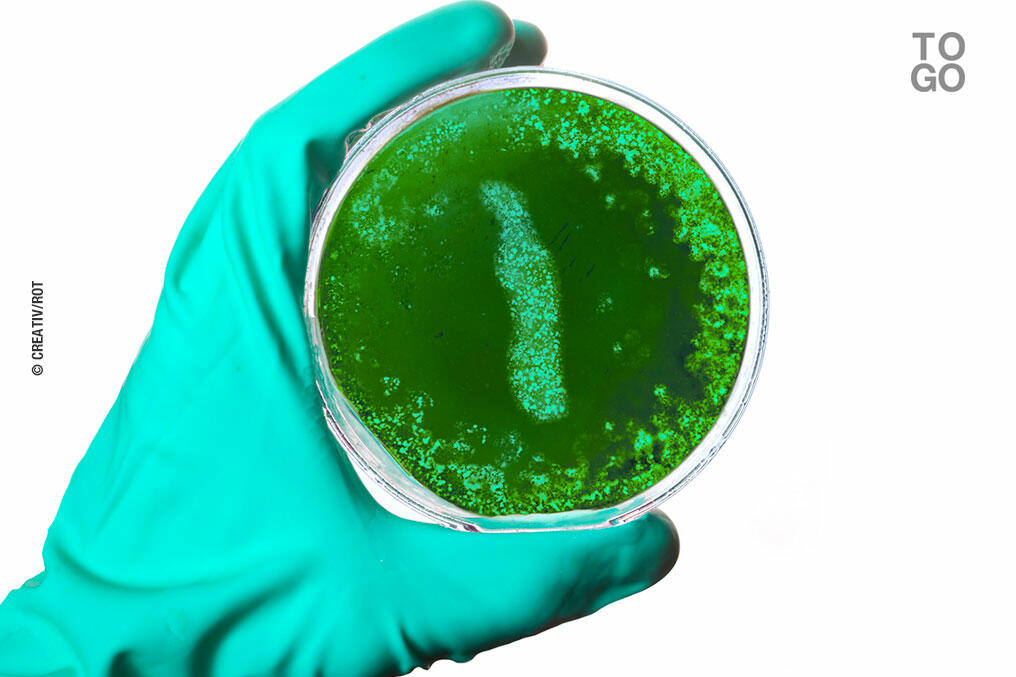

- Diplomatie
Le ministère de la Santé et la représentation de l’OMS (Organisation mondiale de la santé) au Togo viennent de lancer un site dédié au coronavirus (Covid 19).
On peut y trouver de nombreuses informations sur le virus, ses symptômes et les moyens de de protéger.
Figurent également les consignes sanitaires du gouvernement togolais et un décompte des cas avérés dans le pays.
16 personnes sont porteurs à ce jour.





